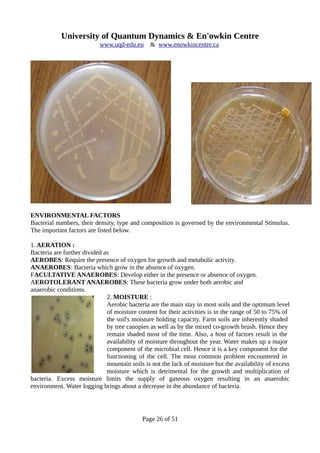
University of Quantum Dynamics & En'owkin Centre
www.uqd-edu.eu & www.enowkincentre.ca
ENVIRONMENTAL FACTORS
Bacterial numbers, their density, type and composition is governed by the environmental Stimulus.
The important factors are listed below.
1. AERATION :
Bacteria are further divided as
AEROBES: Require the presence of oxygen for growth and metabolic activity.
ANAEROBES: Bacteria which grow in the absence of oxygen.
FACULTATIVE ANAEROBES: Develop either in the presence or absence of oxygen.
AEROTOLERANT ANAEROBES: These bacteria grow under both aerobic and
anaerobic conditions.
2. MOISTURE :
Aerobic bacteria are the main stay in most soils and the optimum level
of moisture content for their activities is in the range of 50 to 75% of
the soil's moisture holding capacity. Farm soils are inherently shaded
by tree canopies as well as by the mixed co-growth brush. Hence they
remain shaded most of the time. Also, a host of factors result in the
availability of moisture throughout the year. Water makes up a major
component of the microbial cell. Hence it is a key component for the
functioning of the cell. The most common problem encountered in
mountain soils is not the lack of moisture but the availability of excess
moisture which is detrimental for the growth and multiplication of
bacteria. Excess moisture limits the supply of gaseous oxygen resulting in an anaerobic
environment. Water logging brings about a decrease in the abundance of bacteria.
Page 26 of 51
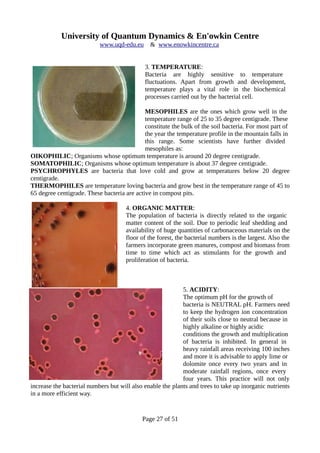
University of Quantum Dynamics & En'owkin Centre
www.uqd-edu.eu & www.enowkincentre.ca
3. TEMPERATURE:
Bacteria are highly sensitive to temperature
fluctuations. Apart from growth and development,
temperature plays a vital role in the biochemical
processes carried out by the bacterial cell.
MESOPHILES are the ones which grow well in the
temperature range of 25 to 35 degree centigrade. These
constitute the bulk of the soil bacteria. For most part of
the year the temperature profile in the mountain falls in
this range. Some scientists have further divided
mesophiles as:
OIKOPHILIC; Organisms whose optimum temperature is around 20 degree centigrade.
SOMATOPHILIC; Organisms whose optimum temperature is about 37 degree centigrade.
PSYCHROPHYLES are bacteria that love cold and grow at temperatures below 20 degree
centigrade.
THERMOPHILES are temperature loving bacteria and grow best in the temperature range of 45 to
65 degree centigrade. These bacteria are active in compost pits.
4. ORGANIC MATTER:
The population of bacteria is directly related to the organic
matter content of the soil. Due to periodic leaf shedding and
availability of huge quantities of carbonaceous materials on the
floor of the forest, the bacterial numbers is the largest. Also the
farmers incorporate green manures, compost and biomass from
time to time which act as stimulants for the growth and
proliferation of bacteria.
5. ACIDITY:
The optimum pH for the growth of
bacteria is NEUTRAL pH. Farmers need
to keep the hydrogen ion concentration
of their soils close to neutral because in
highly alkaline or highly acidic
conditions the growth and multiplication
of bacteria is inhibited. In general in
heavy rainfall areas receiving 100 inches
and more it is advisable to apply lime or
dolomite once every two years and in
moderate rainfall regions, once every
four years. This practice will not only
increase the bacterial numbers but will also enable the plants and trees to take up inorganic nutrients
in a more efficient way.
Page 27 of 51

Evergreen and broad-leaf forests are home to thousands of rare plant and animal species. Scientists have discovered many microorganisms in these areas, though they have just begun to study them. Logging and mining have destroyed forests and caused an ecological collapse, wiping out many beneficial microorganisms. One such group is actinomycetes, microscopic soil organisms that play an important role in degrading organic matter. Actinomycetes thrive in environments with adequate organic matter, neutral-alkaline pH, appropriate moisture, and temperatures around 25-30 degrees Celsius. They contribute significantly to soil health and the well-being of ecosystems.














![University of Quantum Dynamics & En'owkin Centre
www.uqd-edu.eu & www.enowkincentre.ca
hydrogen ion concentrations beyond pH values of 8.0.
MOISTURE:
The moisture requirement varies from species to species. Soils which have relatively high moisture
regimes, suppress the growth and development of certain fungi. Fungi belonging to Basidiomycetes
multiply profusely in wood containing less than 20 % moisture. On the other hand the
Phycomycetous fungi require very high moisture content for its growth and multiplication. Various
moisture regimes determine the fate of spore germination. In general, a high level of moisture
facilitates the germination of spores and other reproductive structures of the fungus.
AERATION:
Mountain soils which are well aerated contain abundant fungi because most of the fungal species
are aerobic.
TEMPERATURE
Most fungal species are mesophilic (25 to 35 degree centigrade). However in compost pits, the
presence of thermophilic fungi is commonly observed. Thermophilic fungi multiply at 50 to 60
degree centigrade but not at 65 degree centigrade.
SEASON:
Since the mountains are exposed to different seasons, it has a very deleterious effect on the fungal
population. The rainy season provides ideal conditions for the proliferation of fungi but in heavy
rainfall regions receiving in excess of 200 inches per annum [includes snow] the growth of fungi are
restricted. December and January are winter months in the mountain area and fungi are at low ebb
during these months.
TYPE OF VEGETATION:
Incorporation of crop residues, green manures and carbonaceous materials improves the microbial
load, particularly the fungal growth. Certain species dominate initially, but subsequently their
numbers decline. Some species maintain high population levels for relatively long periods after the
incorporation of plant residues.
Page 15 of 51](https://image.slidesharecdn.com/251c1b10-8f3e-4f1d-b65f-0908c0544787-151119095403-lva1-app6891/85/Mountain-Ecology-15-320.jpg)


![University of Quantum Dynamics & En'owkin Centre
www.uqd-edu.eu & www.enowkincentre.ca
TABLE 2: Persistence of Viable Fungal Structures in Soil
[Alexander Martin, 1975. Microbial Ecology 2:17-27.]
STRUCTURE FUNGUS PERSISTENCE IN YEARS
CHLAMYDOSPORE TILLETIA >5
OOSPORE APHANOMYCES >10
SCLEROTIUM
MICROSCLEROTIUM
PHYMATOTRICHUM
VERTICILLIUM
>12
14
FUNGI AS BIOCONTROLAGENTS:
The mountain soils are known to contain different species of nematodes. The root lesion nematode,
Pratylenchus coffeae is known to cause great economic damage in most farms including cherry,
berry and tobacco are tolerant. Some species of fungi have developed a mechanism to entrap
nematodes and devour them. It has taken millions of years for fungi to develop tentacles helpful in
fooling predators. It appears that a normal micro flora has an important protective function against
pathogenic and opportunistic microorganisms. Other species of fungi are known to predate over
protozoas.
A PEEP INTO THE FUTURE:
A number of fungi present within the mountain farms have medicinal, theraupetic and high protein
value. Farmers can easily exploit their usefulness by simply learning the behavior of such fungi. An
interesting fact about fungi is that they can be easily mass cultured inside the farm itself without any
sophisticated laboratory equipment. The raw material or the substrates on which the fungus grows is
abundantly available on the farm itself. Farmers have to take extreme care only in the isolation and
identification of pure cultures. Once the pure culture is isolated, the farmer should inoculate a
sample flask or a glass container having the requisite medium with the fungal culture and store it in
Page 18 of 51](https://image.slidesharecdn.com/251c1b10-8f3e-4f1d-b65f-0908c0544787-151119095403-lva1-app6891/85/Mountain-Ecology-18-320.jpg)

![University of Quantum Dynamics & En'owkin Centre
www.uqd-edu.eu & www.enowkincentre.ca
DENITRIFICATION SOIL Pseudomonas,
Achromobacter
TRANSFORMATION OF
VARIOUS
ELEMENTS LIKE IRON,
COPPER
SULPHUR,MANGANESE,
COPPER-COBALT
SULPHIDES, GERMANIUM
SOIL
Thiobacillus,
Ferribacterium,
Aerobacter,Clostridium
Thiobacillus Ferrioxydans
[Cu-Co]
Aerobacter transoxydans [Ge]
Shade grown MOUNTAIN FARMS
have sustained many generations of
farmers because of their resilience in
overcoming all odds. The secret behind
this success is attributed to the microbial
inhabitants. Microorganisms cannot be
seen by the naked eye, yet they
constitute about one quarter of the
biomass-the total weight of living
organisms in the world. Animals and
plants account for the remainder. In the
strict sense, more than 98 % of what we
describe as waste inside the farm is
valuable food for one or the other group
of microorganisms. Bacteria recycle
these wastes into power packed energy rich nutrients required for the survival of the medicine
plants and its partners. Farmers have an erroneous concept of the role of bacteria in nature. They
strongly feel that the majority of bacteria are disease producing. We would like to set the record
straight and state that the vast majority of bacteria are not only beneficial but are absolutely
essential in building up a healthy farm. Yes, there are a very few bacterial species that are harmful
but in a healthy ecosystem they rarely express themselves.
It is very important that the farmer understand the subtle role played by bacteria in the
transformation of major elements like nitrogen, sulfur and phosphorus, biodegradation, neutralizing
toxic wastes, bio-control agents and a host of other activities. Certain bacteria belonging to the
families Thiorhodaceae , Chlorobacteriaceae and Athiorhodaceae contain bacteriochlorophyll and
various carotenoids and are also capable of photosynthesis.
Bacterial interactions with the farm crops and the surrounding flora are known to improve plant
growth and productivity. The fertility of the soil is directly dependent on the activity of soil
microorganisms. The soil microorganisms mineralize insoluble and indiffusable organic
constituents and make them available to plants. The common denominator to assess a healthy soil is
the viable number of soil microorganisms.
The shade grown mountain ecosystem is unique in the true sense that it simultaneously achieves the
Page 32 of 51](https://image.slidesharecdn.com/251c1b10-8f3e-4f1d-b65f-0908c0544787-151119095403-lva1-app6891/85/Mountain-Ecology-32-320.jpg)




![University of Quantum Dynamics & En'owkin Centre
www.uqd-edu.eu & www.enowkincentre.ca
long drawn process and takes time. The build up of humus changes the entire ground scenario
firstly by improving the structural properties of the soil and build up of billions of beneficial
microbes. This in turn leads to a better utilization of the nutrients present by the plants, as well as of
soil moisture. Farmyard manure and compost should be periodically applied to the berry farm, for
this accelerates the decomposition of plant residues and at the same time provides a steady supply
of nutrients. All these cumulative factors aid in the easy establishment and multiplication of
EM.New Clearings or Replanting in Evergreen Plantations; [Tree Farms]
It is quite common to open up new plantations in virgin forests. Also, due to the short life span of
certain varieties of pine, fir, cedars coupled with the heavy infestation of white stem borer, Japenese
Beetle, periodic replanting of different varieties of evergreens are undertaken. Once the replanting is
done, the farmers invariably transport large quantities of humus and leaf litter from an established
plantation block and cover the new clearings as well as the replanted blocks. This practice is
scientifically unsound and detrimental to the evergreen mountains. The planters need to be educated
about such harmful practices because harvesting of humus and biomass in large quantities can
drastically bring down the population of beneficial microbes and such areas are easily susceptible to
pest and disease incidence. Instead, the solution is to add farmyard manure and compost to new
clearings and replanted blocks. This practice maintains a healthy level of EM inside the forest.
Over-watering:
This increases the losses of nutrients by leaching and hence reduces the fertility status of the soil.
This means increased demands for a good humus economy for the proliferation of beneficial
microbes. Since young plants are surface feeders the roots require well aerated soils which in turn
are possible in humus rich soil systems.
Forest Nurseries
During preparation of nursery beds the practice often followed is soil fumigation to kill harmful
pathogens. Unfortunately, this also kills many beneficial microbes. EM application on to such beds
significantly, improves the seedling quality.
World wide research has clearly demonstrated that tree seedlings lacking ectomycorrhizae suffer
nutrient deficiencies early in the growing season. However, with inoculation of EM the deficiency
disappears.
Tree Felling
There is a direct correlation in the reduction of EM with increased tree felling. Forests cleared of
timber are very low in EM activity and are difficult to reclaim unless inoculated with the right kind
of EM. There is every possibility that a particular tree species may be infected by more than one
fungal species. Scientists are a long way in identifying the right kind of EM for various tree species
inside the mountain.
Fertilizers, Pesticides & Chemicals
Fertilizers, pesticides and chemicals are known to have a inhibitory effect on the growth and
development of ecto mycorrhizae. Reduced application of the above mentioned significantly
stimulates EM development.
Page 37 of 51](https://image.slidesharecdn.com/251c1b10-8f3e-4f1d-b65f-0908c0544787-151119095403-lva1-app6891/85/Mountain-Ecology-37-320.jpg)













